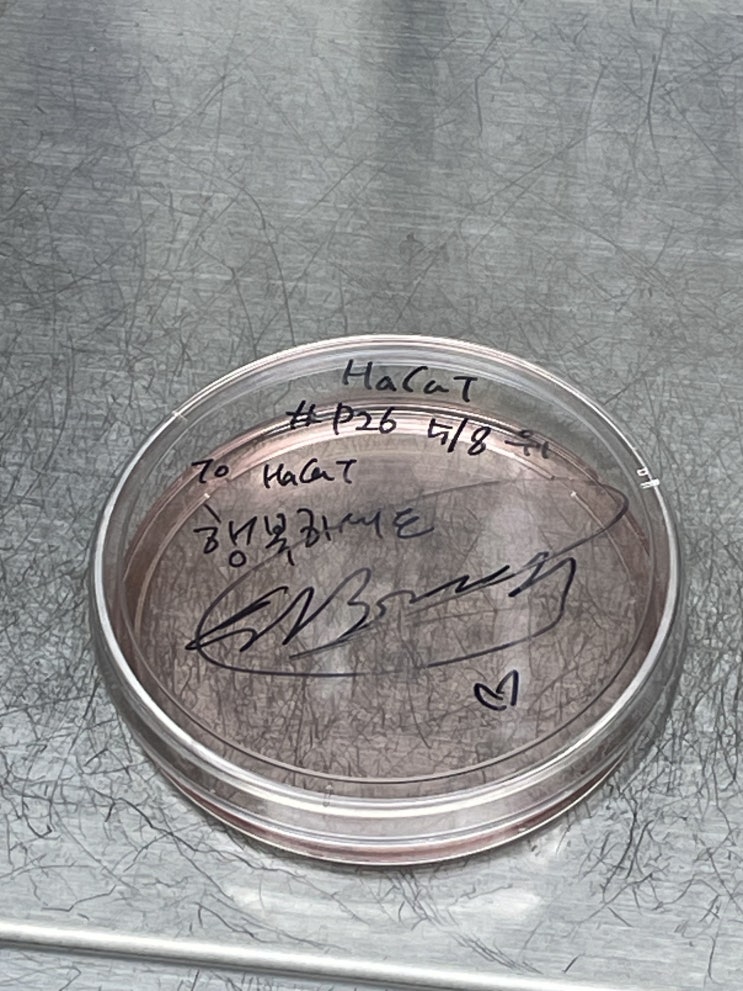

그 어려운걸 해냅니다 내가
2025.06.01

뭘 해냈냐고요? 말도 안되는거요. 이번주는 수영도 과감하게 포기했다 못가.. 애초에 갈 생각도 안함 실행...
출처
https://blog.naver.com/wi1654/223145032414
이슈모어 핫이슈
-
 설현 유튜브 복귀, 4년 만에 다시 열린 일상 기록…배우 김설현의 새로운 변화
설현 유튜브 복귀 소식이 전해지며 배우 김설현의 달라진 행보가 다시 주목받고 있다. 설현은 약 4년이라는 긴…
설현 유튜브 복귀, 4년 만에 다시 열린 일상 기록…배우 김설현의 새로운 변화
설현 유튜브 복귀 소식이 전해지며 배우 김설현의 달라진 행보가 다시 주목받고 있다. 설현은 약 4년이라는 긴…
-
 이선빈 감옥의 맛 주연 확정, 노이즈 흥행 후 박지환과 코미디 승부
이선빈 감옥의 맛 출연 소식이 전해지며 배우 이선빈의 새로운 장르 도전에 관심이 모이고 있다. 이선빈은 새 …
이선빈 감옥의 맛 주연 확정, 노이즈 흥행 후 박지환과 코미디 승부
이선빈 감옥의 맛 출연 소식이 전해지며 배우 이선빈의 새로운 장르 도전에 관심이 모이고 있다. 이선빈은 새 …
-
 김소연 연애의 재발견, 촬영 재정비 속 더 커진 기대감…김지석과 다시 그릴 현실 로맨스
김소연 연애의 재발견 촬영 재정비 소식이 전해지며 JTBC 새 드라마를 향한 관심이 커지고 있다. 배우 김소…
김소연 연애의 재발견, 촬영 재정비 속 더 커진 기대감…김지석과 다시 그릴 현실 로맨스
김소연 연애의 재발견 촬영 재정비 소식이 전해지며 JTBC 새 드라마를 향한 관심이 커지고 있다. 배우 김소…
관련 포스팅
Copyright blog.dowoo.me All right reserved.